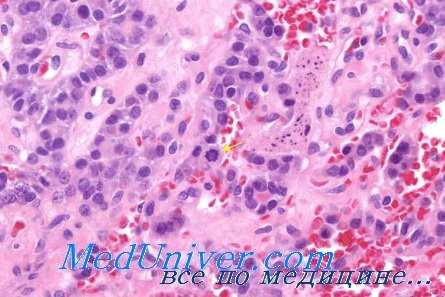
диагностика рака щитовидной железы
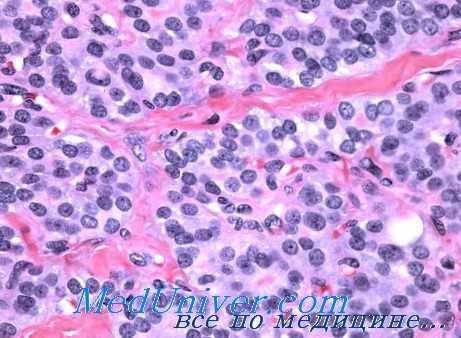
онкоцитарная аденома

Онкоцитарная аденома или аденома из клеток Гюртля. Постбронхиальный рак Гецовой
Добавил пользователь Дмитрий К. Обновлено: 08.11.2025
Диагностика рака щитовидной железы
Известно, что наибольшее число ошибок при микроскопической диагностике опухолей щитовидной железы приходится именно на группу злокачественных новообразований.
Поэтому при микроскопическом изучении опухолей щитовидной железы следует рекомендовать применение дополнительных методов исследования, например срочную диагностику, производимую во время операции па щитовидной железе с целью определения характера патологического процесса. Субоперациопная диагностика тоже является ценным методом, позволяющим в большинстве случаев установить характер новообразования, а, следовательно, дать возможность хирургу определить объем оперативного вмешательства.
Метод экспресс-диагпостики, как показывают М. Н. Торопова и М. М. Тираспольская, полностью оправдывает себя при исследовании опухолей и других локализаций. Этот метод включает в себя макроскопическую оценку, цитологическое или гистологическое исследование препарата. Опытный патологоанатом в отдельных случаях может по внешнему виду новообразования исключить или подтвердить наличие злокачественной трансформации тиреоидной паренхимы. В неясных случаях можно пользоваться также методом цитологического исследования соскоба, взятого с поверхности разреза удаленного новообразования и окрашенного толуидиновым синим (даже без предварительной фиксации мазка).
Этот прием предохраняет от сморщивания и деформации тиреоидные клетки и сохраняет условия нативного препарата. Обнаружение в соскобе значительного количества опухолевых клеток с явлениями атипии и выраженного полиморфизма свидетельствует о злокачественности новообразования. В других случаях соскоб может быть скудным, в нем могут определяться отдельные однотипные тиреоидные клетки, что с определенной долей вероятности говорит о доброкачественном характере опухолевого процесса. Однако наиболее решающим при субонерационпой диагностике опухолей щитовидной железы всо же является гистологическое исследование окрашенных срезов, полученных с помощью замораживающего микротома.
Таким образом, комплексная диагностика, включающая макроскопическую оценку, изучение цитологических мазков или гистологических препаратов, позволяет во время оперативного вмешательства быстро определить характер патологического процесса в щитовидной железе. Однако к оценке таких данных следует относиться с большой осторожностью, так как при обработке материала па замораживающем микротоме значительно деформируются и в известной степени изменяются как клеточные элементы опухоли, так и строма.
К тому же исследование отдельного небольшого кусочка тиреоидной паренхимы, взятого из патологически измененного участка, может не дать полного представления о структуре всей удаленной опухоли. Поэтому результаты срочного (субоперационного) исследования нужно рассматривать как сугубо предварительные, требующие обязательного подтверждения после исследования всего операционного материала.
Учитывая, что возникнуть опухолевый процесс может из небольшого очага атипических клеток, нередко расположенных в толще тиреоидной паренхимы, следует шире использовать метод получения серийных срезов, приготовленных по методу Кристоллора, или же брать для исследования как можно большее количество кусочков опухолевой ткани из разных участков удаленного новообразования.
Заслуживает определенного внимания также метод пункционной биопсии. Цитологическое изучение иунктата щитовидной железы рекомендуют Ф. И. Локшина, И. А. Утратин, Д. Ф. Скрипниченко и И. А. Утратин, Н. И. Никитина, Н. И. Никитина и Н. П. Маслов.
С целью диагностики рака щитовидной железы в последние годы начали использовать метод прижизненной авторадиографии с помощью отпечатков излучения радиоактивного йода на фотоэмульсии. Этот метод находит все большее распространение в клинике заболеваний щитовидной железы. Микроавторадиографии же является наиболее объективным морфологическим способом определения функционального состояния тиреоидной паренхимы при различпых заболеваниях этого органа, в том числе и опухолевых процессах.
Онкоцитарная аденома или аденома из клеток Гюртля. Постбронхиальный рак Гецовой
К сравнительно редко встречающимся доброкачественным новообразованиям щитовидной железы слодует отнести так называемую онкоцитарную аденому, или аденому из клеток Гюртля (постбранхиальный зоб). Описывая данную форму опухоли щитовидной железы, следует отметить, что еще в 1911 г. Лангханс впервые описал несколько случаев злокачественного новообразования щитовидной железы со своеобразной гистологической структурой и назвал их постбранхиальным раком Гецовой.
Термин «постбранхиальный рак, или струма» принадлежит Гецовой, которая описала картину эмбриональной щитовидной железы кретина с остатками эпителиальных телец и центрального капала с постбранхиальными образованиями. Позже эта форма рака получила название «опухоль из клеток Гюртля». В настоящее время большинство патоморфологов строго дифференцируют так называемую пролиферирующую опухоль (струму) Лангханса (рассматривая ее как явно злокачественное новообразование щитовидной железы) от аденомы из клеток Гюртля или онкоцитарной аденомы, являющейся согласно международной номенклатуре доброкачественной опухолью, хотя некоторые отечественные авторы (Р. М. Пропп) склонны и теперь трактовать ее как злокачественную. Мы можем согласиться лишь с тем, что данное доброкачественное новообразование щитовидной железы нередко подвергается малигнизации. В патологоанатомической практике онкоцитарная аденома встречается не так уже редко.
Этот вид опухоли содержит очень крупные полиморфные клетки с отчетливо выраженной ацидофильной мелкозернистой протоплазмой. Онкоцитарная аденома микроскопически имеет преимущественно фолликулярное строение, иногда тубулярное или трабекулярпое. В последнем случае структура опухолевой паренхимы вследствие отчетливой зозинофилии клеток несколько напоминает строение печеночных балок, при этом почти полностью утрачивается фолликулярное строение. Внутрифолликулярный коллоид в онкоцитарных аденомах щитовидной железы преимущественно жидкий, местами резорбирован.
Строма опухоли обычно скудно развита и состоит из нежных соединительнотканных прослоек (G. Crile, I. Hazard, В. Dinsmore, О. Соре, В. Bobyns, E. Hamlin, I. Hopkirk, P. Fitzequrald, F. Foote, В. А. Одинокова, А. Г. Калинина).
Следует подчеркнуть, что указанная онкоцитарная опухоль, являясь доброкачественной, нередко подвергается малигнизации и способна к метастазированию. Поэтому некоторые авторы (С. Ваrthels, F. Mazzeo) склонны рассматривать ее как полузлокачественное или даже злокачественное новообразование щитовидной железы.
Ультраструктура доброкачественных новообразований щитовидной железы не имеет специфических черт. В клетках опухолей, имеющих высокую функциональную активность, резко расширен эндоплазматический ретикулум, среди которого выявляются сравнительно крупные цистерны. В большом количестве встречаются секреторные гранулы и осмиофильныо тельца. Количество митохондрий резко увеличено, но их форма и размеры не подвергаются заметным деструктивным изменениям. Ядра клеток обычно сочные, набухшие, перинуклеарное пространство почти не определяется.
Как отмечают R. Stoll, H. Maraud, A. Sparfeld, М. Milson, A. Lupesku, N. Dmitrieva, Н. David, хроматин ядра в одних опухолевых клетках распределяется более или менее равномерно, в других накапливается в одном из полюсов клетки. Часто можно наблюдать два или три увеличенных ядрышка.
К доброкачественным опухолям щитовидной железы относятся встречающиеся очень редко кисты, развивающиеся из остатков эмбрионального щитовидно-язычного протока.
Учитывая большое разнообразие структурных разновидностей аденом щитовидной жолезы, а также то, что гистологическое строение их нередко находится в резком противоречии с клиническим проявлением заболевания, поставить правильный патоморфологический диагноз обычно очень трудно. Учитывая, что аденомы этого органа очень часто склонны к малигнизации, каждый узел щитовидной железы, представляющий собой доброкачественное новообразование, нужно рассматривать как потенциальное предраковое состояние.
Аденома бронха
Аденома бронха – это новообразование, исходящее из эпителия протоков и слизистых желез бронхиальной стенки. Клинически аденома бронха проявляется одышкой, стридорозным дыханием, кашлем, кровохарканьем, признаками воспаления дыхательных путей. Аденоматозная опухоль бронха выявляется по данным рентгенографии, томографии, бронхоскопии и бронхографии, эндоскопической биопсии. Новообразование подлежат хирургическому удалению; в зависимости от клинической ситуации может выполняться эндоскопическое удаление опухоли, циркулярная либо окончатая резекция бронха, различные виды резекции легких, пневмонэктомия.
МКБ-10
Общие сведения
Опухоли, развивающиеся в бронхах, могут быть как доброкачественными, так и злокачественными. К числу злокачественных опухолей относят бронхогенный рак легких. Доброкачественные опухоли бронхов, в основном, представлены аденомами. В целом, доброкачественные новообразования бронхов встречаются значительно реже злокачественных, примерно в 5-10% случаев в общей структуре опухолевых поражений дыхательных путей.
Среди доброкачественных опухолей аденомы составляют около 60–65%. Бронхиальные аденомы относятся к опухолям эпителиального типа, развивающимся преимущественно из желез слизистой оболочки бронхиального дерева. В пульмонологии аденому бронха рассматривают как доброкачественную опухоль с высоким потенциалом злокачественности, т. к. различные виды аденом склонны к рецидивированию и малигнизации. Аденома бронха чаще диагностируется у женщин в возрасте 35-50 лет.
Причины
Достоверные причины возникновения аденом бронха неизвестны. Предполагается, что в их развитии могут играть роль следующие факторы:
- Экзогенные влияния. Курение (активное и пассивное), профессиональные факторы (работа с мышьяком, никелем, асбестом и др.), экологическое неблагополучие.
- Болезни бронхов и легких. Не исключается патогенетическая связь аденомы бронха с другой бронхолегочной патологией: ХОБЛ, бронхиальной астмой, хроническим бронхитом, рецидивирующими и затяжными пневмониями и др.
- Гормональный дисбаланс. Учитывая, что аденомы любых локализаций (аденома простаты, молочной железы, щитовидной железы, слюнных желез, ЖКТ, бронха) возникают из железистого эпителия, вероятно участие эндокринных механизмов в их возникновении.
Классификация
В морфологическом плане «аденома бронха» – собирательное понятие, включающее опухоли разнообразные по строению и клеточному составу. С учетом патогистологической структуры различают несколько типов аденом бронха: карциноидный, мукоэпидермоидный, цилиндроматозный и смешанный.
Более чем в 80% в клинической практике встречаются аденомы карциноидного типа (карциноиды бронха). По своему микроскопическому строению они представлен пролиферирующими клетками, исходящими из ресничного эпителия или бронхиальных желез. Характерно присутствие в клетках значительного числа аргентаффинных (окрашиваемых солями серебра) структур, что позволяет причислять данный тип аденомы бронха к типичным карциноидам.
В месте произрастания карциноида имеется большое количество сосудов, что объясняет наклонность опухоли к геморрагиям. Аденома обычно прочно связана со стенкой бронха и в ряде случаев проникает глубоко в ее толщу. Предполагается, что карциноидами бронхов, как и карциноидами пищеварительного тракта, секретируется серотонин и адреналин, поэтому данная разновидность аденомы бронхов может вызывать вегетативные нарушения: чувство жара, головокружения, приступы бронхоспазма, аллергические дерматозы и др.
Среди карциноидных аденом бронха различают типичный высокодиффренцированный карциноид, атипичный умеренно дифференцированный и анаплазированный низкодифференцированный карциноид. Малигнизация карциноидных аденом бронха происходит в 5–10% случаев. Для злокачественного карциноида характерен инфильтративный рост и способность к гематогенному и лимфогенному метастазированию в отдаленные органы - другое легкое, головной мозг, печень, кости, почки, поджелудочную железу. В отличие от бронхогенного рака, злокачественная аденома бронха отличается медленным ростом и поздним метастазированием, а ее радикальное удаление дает хорошие отдаленные результаты.
Второе место по частоте выявляемости (около 10%) занимают аденомы бронха цилиндроматозного типа (цилиндромы). Микроскопически они состоят из цилиндрического или призматического эпителия. Значительно реже (менее 1%) встречаются аденомы бронха мукоэпидермоидного типа (мукоэпидермоиды), представленные железисто-кистозными образованиями, заполненными слизистой массой. Аденомы бронха смешанного типа сочетают строение цилиндром и карциноидов. По локализации различают центральные и периферические аденомы бронха.
Патогенез
Среди аденом бронха наименее злокачественное течение свойственно карциноидным опухолям. Аденомы бронха обычно достигают размеров 2-3 см в поперечнике, имеют гладкую, иногда дольчатую поверхность розовато-красного цвета. Аденомы могут иметь эндобронхиальный, внебронхиальный (экстрабронхиальный) и смешанный рост. Эндобронхиальная аденома растет в просвет бронха, приподнимая слизистую оболочку, вызывая ее атрофические изменения и изъязвление.
Эндобронхиальный рост сопровождается нарастанием бронхиальной обструкции, вплоть до полного закрытия просвета бронха. По мере роста опухоли может возникать ателектаз легкого, развиваться хроническая пневмония с частыми обострениями, пневмосклероз, бронхоэктазы. Внебронхиальный рост аденомы бронха характеризуется распространением опухоли в толщу бронхиальной стенки или наружной локализацией.
При смешанном характере роста аденома бронха имеет вид песочных часов, гантели или айсберга; при этом эндобронхиальную и внебронхиальную части опухоли разделяет перетяжка между раздвинутыми и разрушенными хрящами бронха. В 60% случаев аденомы поражают долевые либо сегментарные бронхи; в 20% - главные бронхи; еще в 20% - бронхиолы.
Симптомы аденомы бронха
Выраженность симптомов зависит от локализации опухоли, степени бронхиальной обструкции, развития осложнений. В клиническом течении центральной аденомы бронха выделяют три периода. В первом периоде аденома не вызывает грубого нарушения бронхиальной проходимости. Клинические проявления включают сухой кашель, общее недомогание, кровохарканье.
Во втором периоде, связанном с резким нарушением проходимости бронха, развиваются патологические изменения в легочной ткани и плевре (повторные бронхопневмонии, ателектазы, плевриты), одышка, стридорозное или свистящее дыхание, кашель с мокротой, повышение температуры, легочные кровотечения. Третий период характеризуется полной обтурацией просвета бронха аденомой, что сопровождается развитием стойкого ателектаза легкого с постстенотической бронхоэктазией и присоединением гнойной инфекции.
Карциноиды бронха в 2-4% случаев сопровождаются развитием карциноидного синдрома. В этом случае периодически возникают приливы крови к голове и верхним конечностям, чувство жара, розовато-красные пятна на коже лица, бронхоспазм, колебания АД, приступообразные боли в животе, диарея. Тяжесть и частота приступов возрастает при малигнизации аденомы бронха карциноидного типа.
Диагностика
Аденома бронха не всегда своевременно обнаруживается при профилактической флюорографии. Даже на рентгенограммах, при локализации аденомы в главных и долевых бронхах, патологические изменения, как правило, невидны; лишь на томограммах могут определяться дефекты бронхиальной стенки. Рентгенологическая картина при аденоме бронха зависит от степени бронхиальной обструкции, калибра пораженного бронха, продолжительности течения процесса.
При полной обтурации бронха рентгенография легких выявляет частичный или полный ателектаз легкого; в случае частичной непроходимости определяются признаки гиповентиляции. Наиболее убедительные данные за аденому бронха получают при КТ и МРТ легких, сцинтиграфии легких. Уточнить характер новообразования и его взаимоотношения со стенкой бронха позволяет рентгенконтрастное исследование - бронхография.
В большинстве случаев окончательной диагностике аденомы бронха способствует проведение диагностической бронхоскопии с биопсией. В случае эндобронхиального роста удается визуализировать округлое образование розового цвета с блестящей гладкой или мелкобугристой поверхностью, легко кровоточащее при контакте. Аденома бронха, имеющая ножку, обладает высокой подвижностью; в том случае если опухоль растет на широком основании или имеет вид «айсберга» сместить ее при бронхоскопии не удается.
Проведение эндоскопической биопсии с последующим гистологическим исследованием позволяет уточнить тип аденомы бронха и степень ее доброкачественности. С целью оценки тяжести обструктивных и рестриктивных нарушений выполняется спирометрия. Для исключения аденом иной локализации целесообразно проведение ТРУЗИ (у мужчин), УЗИ молочных желез (у женщин), ЭГДС, колоноскопии, УЗИ щитовидной железы, почек и надпочечников, слюнных желез.
Лечение аденомы бронха
Ввиду опасности осложнений (нагноительного процесса, кровотечения, малигнизации), аденомы бронхов подлежат хирургическому удалению в максимально ранние сроки. Характер и объем вмешательства определяется локализацией, размерами, особенностями роста, гистологической структурой аденомы бронха, развитием вторичных изменений легочной ткани.
В раннем периоде, при заведомо доброкачественной аденоме бронха центральной локализации с эндобронхиальным ростом, имеющей тонкую ножку, может быть произведено эндоскопическое удаление опухоли. Однако эндобронхиальное вмешательство сопряжено с вероятностью недостаточной радикальности операции, высоким риском кровотечения, необходимостью повторного эндоскопического контроля и биопсии бронха.
В большинстве случаев удаление аденомы бронха на узкой ножке производят путем бронхотомии или окончатой резекции бронха. При аденомах, имеющих широкое основание, показана циркулярная резекция бронха с наложением межбронхиального анастомоза. Данные типы операций, ограничивающиеся экономной резекцией бронха, могут быть выполнены только при гистологически подтвержденных доброкачественных образованиях и функционально полноценной легочной ткани.
В случае ограниченных необратимых изменений легочной ткани дистальнее обтурации бронха опухолью (бронхоэктазов, постстенотических абсцессов легкого, фиброза), производится краевая резекция, сегментэктомия, лобэктомия или билобэктомия. При патологических изменениях во всем легком единственно возможным вмешательством является пневмонэктомия.
Прогноз
Несвоевременная диагностика аденомы бронха исключает возможность проведения щадящих операций и диктует необходимость выполнения масштабных резекций легкого. После радикальной резекции аденомы бронха 5-летняя выживаемость составляет 96%. В отдельных случаях возможны местные рецидивы, малигнизация опухоли и отдаленное метастазирование аденомы бронха. Пациенты, перенесшие удаление аденомы бронха, должны находиться под наблюдением пульмонолога (торакального хирурга), проходить регулярный рентгенологический и эндоскопический контроль.
Аденома щитовидной железы
Аденома щитовидной железы – доброкачественное узловое новообразование тиреоидной ткани. Аденома щитовидной железы может протекать бессимптомно либо проявляться признаками гипертиреоза (снижением массы тела, слабостью, тахикардией, потливость и др.), компрессией органов шеи. Диагностика аденомы щитовидной железы заключается в проведении УЗИ, гормональных исследований (Т3, Т4, ТТГ, ТГ), рентгеноскопии пищевода, пункционной биопсии железы и цитологического исследования материала, сцинтиграфии. При аденоме может быть рекомендована тиростатическая терапия с последующей операцией (удалением узлового образования щитовидной железы, гемитиреоидэктомией) или лечение радиоактивным йодом.
Аденома щитовидной железы — условно доброкачественная, инкапсулированная опухоль, происходящая из тиреоидного эпителия и характеризующаяся самостоятельным ростом и функционированием. На долю аденомы щитовидной железы в эндокринологии приходится от 45 до 75% всех узловых образований щитовидной железы. Опухоль в 4 раза чаще развивается у женщин; средний возраст пациентов с аденомой - 45-55 лет. Аденомы щитовидной железы, в зависимости от своей гормональной активности, могут протекать на фоне эутиреоидного состояния или приводить к развитию гипертиреоза (тиреотоксикоза). Аденома щитовидной железы относится к опухолям, обладающим потенциальной злокачественностью, т. е. возможностью трансформации в рак щитовидной железы.
Причины и механизмы развития аденомы щитовидной железы недостаточно ясны. В патогенезе данного процесса не исключается роль гиперсекреции тиротропина, нарушения регионарной симпатической иннервации, мутация гена, кодирующего рецепторы тиреотропного гормона гипофиза.
Функционирующие аденомы щитовидной железы часто развиваются на фоне ранее существовавшего нетоксического узла. Из этого следует, что факторами риска могут являться проживание в районах с низким содержанием йода в воде и почве, наличие узлового эутиреоидного зоба, наследственная предрасположенность. Пусковым моментом к развитию аденомы щитовидной железы часто служат травмы области шеи (ушибы, гематомы). Нередко аденомы щитовидной железы развиваются на фоне аутоиммунных заболеваний.
Патанатомия
Аденомы щитовидной железы обычно растут моноцентрично, в виде одиночного узла, имеют медленное многолетнее развитие. Вначале функция аденомы не нарушает гормональный баланс; образование отражается на сцинтиграммах в виде «холодного» или «теплого» узла. По мере увеличения размеров узла и возрастания его функциональной активности по механизму обратной связи начинает тормозиться секреция ТТГ.
Интактная часть тиреоидной ткани со временем атрофируется и становится нефункционирующей, а при сцинтиграфии щитовидной железы обнаруживается накопление радиоактивного йода в области гиперфункционирующей аденомы («горячий» узел). В это время у больного развиваются признаки тиреотоксикоза. Нефункционирующие аденомы щитовидной железы трансформируются в токсические в 10% случаев.
В зависимости от морфологического строения различают фолликулярную, папиллярную, оксифильную, функционирующую, светлоклеточную и др. виды аденомы щитовидной железы. Источником развития аденом служат А- и В-фолликулярные клетки щитовидной железы. Наиболее распространенные виды аденом:
- Фолликулярные. Представляют собой округлые инкапсулированные узлы, плотноэластической консистенции, обладающие достаточной подвижностью. Среди эутиреоидных узловых образований железы они составляют 15-20%. К фолликулярным образованиям относятся такие разновидности, как коллоидная (макрофолликулярная), микрофолликулярная, фетальная, трабекулярная (эмбриональная) аденома щитовидной железы.
- Папиллярные. Такие аденомы щитовидной железы имеют кистозное строение; внутри кист выявляются сосочковидные разрастания, окруженные коричневатой жидкостью.
- Функционирующие (токсические). Эти аденомы сопровождаются развитием болезни Пламмера – избыточной продукцией тиреоидных гормонов (Т3 и Т4), подавляющих секрецию тиреотропного гормона гипофизом. Клинически проявляется признаками гипертиреоза.
- Онкоцитарные. Аденома, развивающаяся из В-клеток (оксифильная аденома из клеток Гюртле-Асканази, опухоль Лангханса), имеет наиболее агрессивное течение и в 10-35% случаев при гистологическом исследовании оказывается злокачественной.
Симптомы
Нефункционирующая аденома щитовидной железы длительное время остается бессимптомной и часто выявляется эндокринологом на рутинном медицинском осмотре или при проведении УЗИ щитовидной железы. В этом случае при пальпации шеи обнаруживается солитарное узловое образование одной из долей щитовидной железы: безболезненное, подвижное, плотное или мягкоэластическое.
При увеличении размеров аденомы щитовидной железы может отмечаться видимая деформация шеи, компрессионный синдром - чувство давления, дисфагия, одышка. Длительное течение аденомы может сопровождаться ее кальцификацией и оссификацией, развитием узлового токсического зоба, злокачественным перерождением, кровоизлиянием в ткань аденомы, инфицированием гематомы.
Развитие токсической аденомы щитовидной железы сопровождается снижением массы тела при обычном образе жизни и питании, потливостью, тремором, быстрой утомляемостью при физической нагрузке, плохой переносимостью тепла и жары. У больных отмечается повышенная эмоциональная лабильность, раздражительность, тревожность, бессонница, плаксивость. Типично возникновение синусовой тахикардии или мерцательной аритмии, приступов стенокардии, артериальной гипертензии.
В дальнейшем может присоединяться левожелудочковая, а затем правожелудочковая сердечная недостаточность (отеки, гепатомегалия). Нередко отмечаются лихорадочные состояния, расстройства функции ЖКТ, экзофтальм. При гипертиреозе, вследствие дисбаланса половых гормонов, у мужчин может развиваться гинекомастия и снижение потенции; у женщин – нарушения менструального цикла и бесплодие.
С целью подтверждения и верификации диагноза аденомы щитовидной железы проводятся лабораторные и инструментальные исследования:
- УЗИ щитовидной железы. Определяется размер, количество, локализация узлов.
- Радиоизотопное сканирование. Показывает степень функциональной активности аденомы в зависимости от поглощения узлом радиойода («холодный», «теплый» или «горячий» узел).
- Анализ на гормоны. При токсической аденоме щитовидной железы уровень ТТГ в сыворотке крови снижен; Т3 и Т4 – повышен или находится на верхней границе нормы. При нефункционирующей аденоме уровни гормонов остаются нормальными.
- Биохимический анализ крови. Определяется гиполипидемия, нарушение толерантности к глюкозе.
- Гистологическое исследование. Окончательное подтверждение диагноза и определение морфологической формы аденомы производится по результатам тонкоигольной аспирационной биопсии и исследования клеточного состава опухоли. В 80% случаев биопсия позволяет дифференцировать аденому и рак щитовидной железы.
При компрессии структур шеи выполняется рентгенография пищевода с барием. В случае тиреотоксикоза проводится обследование сердца (ЭКГ, ЭхоКГ), печени и почек (биохимический анализ крови, УЗИ). В процессе диагностики исключаются другие поражения щитовидной железы – многоузловой зоб, аутоиммунный тиреоидит, рак щитовидной железы.
Лечение аденомы щитовидной железы
Аденомы щитовидной железы подлежат хирургическому удалению. Консервативное лечение допускается лишь при коллоидной аденоме, преимущественно в период беременности, поскольку данный вид опухоли реже малигнизируется.
Операция должна выполняться на фоне эутиреоидного состояния, поэтому при тиреотоксикозе проводится предварительное медикаментозное лечение тиростатическими препаратами (карбимазол, тиамазол, пропилтиоурацил). В предоперационном периоде рекомендуется психический покой, диета, обогащенная белками и витаминами, полноценный сон, фитотерапия; запрещается принимать солнечные ванны и посещать солярий.
По достижении эутиреоза производится энуклеация узла щитовидной железы со срочным гистологическим исследованием аденомы. При поражении значительной части щитовидной железы или малигнизированных формах аденомы объем операции расширяют до гемитиреоидэктомии, субтотальной резекции щитовидной железы, или тиреоидэктомии.
У пожилых пациентов или при противопоказаниях к хирургическому лечению аденомы щитовидной железы применяется терапия радиоактивным йодом. В некоторых случаях успешным является склерозирование аденоматозного узла с помощью инъекционного введения этилового спирта. Это приводит к гибели опухолевых клеток и деструкции аденомы щитовидной железы.
Своевременное комплексное обследование и индивидуализированное лечение аденомы щитовидной железы обеспечивают полное выздоровление. После тотального удаления щитовидной железы необходима пожизненная заместительная терапия – прием тиреоидных гормонов. После операции необходимо диспансерное наблюдение у эндокринолога, периодический контроль гормонов щитовидной железы, отказ от вредных привычек, избегание чрезмерной инсоляции.
Аденома слюнной железы
Аденома слюнной железы – это доброкачественное образование, развивающееся из эпителиоцитов выводных протоков малых и больших слюнных желез. Сопровождается возникновением безболезненного узла округлой формы в проекции железы. При значительных размерах новообразования возникает асимметрия лица, припухлость, ноющие боли, парестезии кожи. Диагностируется аденома с помощью общеклинических и специальных методов исследования: УЗИ слюнной железы, контрастной сиалографии, гистологии, томографии. Лечение аденом осуществляется исключительно хирургическим путем: в зависимости от размера опухоли проводится полное или частичное иссечение железы.
В хирургической стоматологии описано несколько гистологических типов аденом слюнных желез. Наиболее часто в клинической практике диагностируется плеоморфная аденома. Она составляет 50-70% эпителиальных новообразований больших слюнных желез (обычно околоушных) и 20-55% - малых (преимущественно нёбных). Аденома обычно возникает у людей преклонного возраста (после 50-60 лет), чаще у женщин.
Растет в течение длительного времени ‒ 10-12 лет. Плеоморфную аденому слюнной железы также называют смешанной опухолью из-за морфологической разнородности структуры. Новообразование является доброкачественным, но может малигнизироваться. Перерождение в злокачественную форму встречается в 2-5% случаев. После нерадикального лечения опухоль нередко рецидивирует.
Этиология аденомы изучена не до конца. Существует несколько теорий возникновения заболевания: физико-химическая, вирусная, полиэтиологическая. Каждая теория является правомочной, но ни одна из них не может точно объяснить возникновение аденомы и охватить все причины болезни. На сегодняшний день самой популярной и логичной является полиэтиологическая концепция, согласно которой, действие различных факторов может привести к нарушению работы клеток. Теории образования аденом:
- Физико-химическая. Опирается на положение о пусковой роли в процессе канцерогенеза различных экзогенных веществ. К канцерогенам относят некоторые химические соединения, ионизирующую радиацию, ультрафиолетовое излучение, воздействие холода. Риск образования аденом возрастает после травмы или воспаления слюнной железы (сиаладенита).
- Вирусная. Указывает на связь патологии с инфицированием организма определенными вирусами (Эпштейна-Барр, герпеса), которые провоцируют возникновение опухоли. Согласно данной теории, канцерогены создают благоприятную среду для инвазии и размножения онкогенных вирусов.
- Полиэтиологическая. Основывается на наличии множества этиологических факторов, которые могут вызывать новообразование. Кроме канцерогенов и вирусов, указанных выше, к ним относятся генные мутации, нарушение эмбриональной закладки желез, гормональные нарушения, вредные привычки.
После 45 лет в организме человека происходит иммунная и эндокринная перестройка. Данное состояние в сочетании с нарушением процессов пролиферации и дифференциации клеток делают организм уязвимым для развития опухолевого процесса. Согласно полиэтиологической теории, под действием различных факторов в клетках эпителия слюнной железы возникают процессы ката- и анаплазии. Происходит нарушение дифференциации клеток, которые начинают неконтролируемо размножаться, что приводит к формированию аденомы.
Макроскопически аденома представляет собой эластичный или плотный узел размером 5-6 см. Образование ограничено капсулой, но может прорастать в ткани железы. Наличие капсулы и дольчатое строение можно проследить не всегда. На разрезе аденома может иметь белесоватый, желтоватый или серый оттенок с хрящевидными и слизистыми компонентами. Микроскопически ткань аденомы очень разнородна, представлена железистыми, трабекулярными, солидно-альвеолярными и микрокистозными структурами, миксоидным и ходндроидным веществом.
Аденомы составляют до 80% всех эпителиальных новообразований желез. Для них характерен доброкачественный рост, медленное развитие, возникновение после 50 лет. По морфологическом и гистологическому строению аденомы бывают следующих видов:
- Плеоморфная. Является самой распространенной. Образуется из эпителия выводных протоков. Пальпаторно определяется как круглое образование с плотной текстурой и бугристой поверхностью.
- Мономорфная. Опухоль состоит преимущественно из железистого компонента слюнной железы. Имеет размер до 5 см, мягкая и эластичная при пальпации.
- Аденолимфома. Возникает из лимфатических протоков или узлов, содержит лимфу. Образуется исключительно в околоушной области. Для нее характерны четкие границы, эластичная или плотная структура, склонность к нагноению.
- Оксифильная (онкоцитома). Возникает в 1% случаев, преимущественно в околоушных железах. При пальпации определяется как четко ограниченный эластичный узелок.
- Базальноклеточная. Возникает из базалоидного вида ткани и содержит базальные клетки. Макроскопически является плотным узлом. От других аденом отличается тем, что никогда не рецидивирует и не озлокачествляется.
- Каналикулярная. Появляется чаще на слизистой оболочке верхней губы или щеки. Состоит из призматических клеток эпителия в виде пучков. Отличается маленьким размером, внешне напоминает бусины.
- Сальная. Это небольшой узелок, состоящий из кистозно-измененных сальных клеток. Образование безболезненное, не рецидивирует после удаления.
Образование может возникать в любых слюнных железах: околоушных, подчелюстных, подъязычных или малых – на слизистой губ, щек, неба. Плеоморфная аденома чаще поражает одну из околоушных желез. Опухоль появляется ниже виска, спереди от ушной раковины. Для аденомы характерен медленный рост и длительное существование. Патогномоничными симптомами являются наличие круглого или овального уплотнения, четкие очертания, подвижность и безболезненность при пальпации.
На начальных этапах опухоль может не беспокоить. По мере роста аденомы появляются неприятные и болезненные ощущения, припухлость, отек, снижение слюноотделения и сухость в полости рта. Большие опухоли могут вызывать асимметрию лица, сдавливать окружающие органы, провоцировать ноющие боли. Аденома околоушной железы может травмировать нервные окончания, становясь причиной парестезии кожи и паралича мимических мышц.
Большие новообразования вызывают деформацию глотки, что проявляется неприятными ощущениями во время приема пищи и глотания. Поражение подъязычных желез вызывает у пациентов ощущение инородного тела во рту и нарушения речи. Опухоль малых слюнных желез характеризуется малоподвижностью.
Осложнения
Аденомы больших размеров выходят за пределы капсулы и прорастают вглубь железы. Происходит замещение тканей железы и нарушение функции слюноотделения. Возможны поражения лицевого и тройничного нервов, которые грозят невритом, парезом и параличом мышц. В случае несвоевременного и нерадикального хирургического лечения значительно возрастает риск рецидивирования аденомы.
При длительном существовании опухоли у 5% больных происходит ее малигнизация. При трансформации аденомы в злокачественную возникает стремительное разрастание тканей, образование становится неподвижным и твердым. Беспокоят самопроизвольные болезненные ощущения, снижение выработки слюны, дисфагия. В 50% случаев злокачественное новообразование метастазирует в лимфатические узлы.
С целью диагностики аденомы применяются клинические и специальные методы исследования. Первичный осмотр и опрос больного осуществляет стоматолог-хирург или онколог. Дифференциальную диагностику аденомы проводят с кистами, лимфаденитом, сиаладенитом, злокачественными опухолями слюнных желез. Применяются следующие методы обследования и диагностики:
- Осмотр и зондирование. Путем пальпации определяется место расположения, структура, форма, подвижность, размеры, контуры образования; оценивается наличие болезненных ощущений, отношение опухоли к окружающим органам. Ретроградное зондирование дает возможность определить наличие образования в протоках, степень сдавления железы опухолью. Оценка слюноотделительной функции производится с помощью зонда и массажа железы.
- Контрастная рентгенография. Сиалография показывает точную локализацию и размер новообразования в 83%. Доброкачественные образования оттесняют протоки, которые совпадают с контурами опухоли. По контурам судят о размере аденомы. Прерывистое контрастирование протоков характерно для злокачественных образований.
- Эхография. УЗИ слюнных желез позволяет судить о размере опухоли и ее структуре. По эхогенности определяют структурные изменения железы, степень замещения соединительной тканью. Доброкачественные образования имеют ровные и четкие контуры. Исследование менее точное при глубоком расположении аденомы.
- Гистологическое и цитологическое изучение. Проводятся после аспирационной биопсии и получения пунктатов опухоли. Позволяют верифицировать опухоль, уточнить клеточный состав, определить вид аденомы, дифференцировать доброкачественные и злокачественные образования.
- Томография. КТ и МРТ слюнных желез дают точную и полную информацию о заболевании. Компьютерная и магнитно-резонансная томография имеют наиболее высокую диагностическую ценность, показывают отношение опухоли к окружающим тканям, стадию развития, уточняют топографо-анатомическую локализацию.
Лечение аденомы слюнной железы
Лечение проводится преимущественно хирургическим путем. Методика операции зависит от клинического течения болезни, размера и расположения аденомы, возраста и состояния здоровья пациента. Труднее всего удалить аденому околоушной области, что обусловлено сложной анатомией данной области. В процессе операции важно правильно выделить и сохранить лицевой нерв. В челюстно-лицевой хирургии используются следующие способы оперативного вмешательства:
- Энуклеацияопухоли. Удаление аденомы предполагает вылущивание и устранение опухоли в пределах ее оболочки. Производят рассечение капсулы железы, отслойку оболочки опухоли от окружающих тканей по всему периметру. Новообразование постепенно препарируют и удаляют. Способ является наименее травмирующим.
- Иссечение железы. Паротидэктомия может быть частичной (удаление опухоли и небольшой подлежащей части железы), субтотальной (экстирпация аденомы вместе с несколькими долями железы) и тотальной (экстирпация околоушной железы с опухолью). При плеоморфной аденоме специалисты рекомендуют проводить тотальную паротидэктомию, т. к. образование склонно к озлокачествлению и рецидивированию. Современные технологии позволяют выполнять операцию с применением лазера, микроскопа и компьютерных технологий. Вмешательство осуществляется малотравматично, а период реабилитации проходит легче.
Прогноз и профилактика
После оперативного удаления аденомы прогноз для жизни и здоровья благоприятный. Послеоперационный период длится 7-10 дней. Осложнения после хирургического лечения возникают крайне редко. После тотальной паротидэктомии возможность рецидива снижается до 1-4%. В случае повторного образования аденомы хирургическое вмешательство проводят вновь в более радикальном объеме. Специфической профилактики заболевания не существует. К мерам общей профилактики относят предупреждение канцерогенных воздействий, заболеваний слюнных желез, травматических повреждений, соблюдение принципов здорового питания и образа жизни.
3. Анализ причин рецидивов доброкачественных опухолей слюнных желез/ Дрегалкина А.А. Коковина Т.А.// Проблемы стоматологии. - 2014.
4. Рецидивы опухолей околоушных слюнных желез (клиника, диагностика, лечение): Автореферат диссертации/ Матякин Е.Г. - 2011.
Читайте также:
